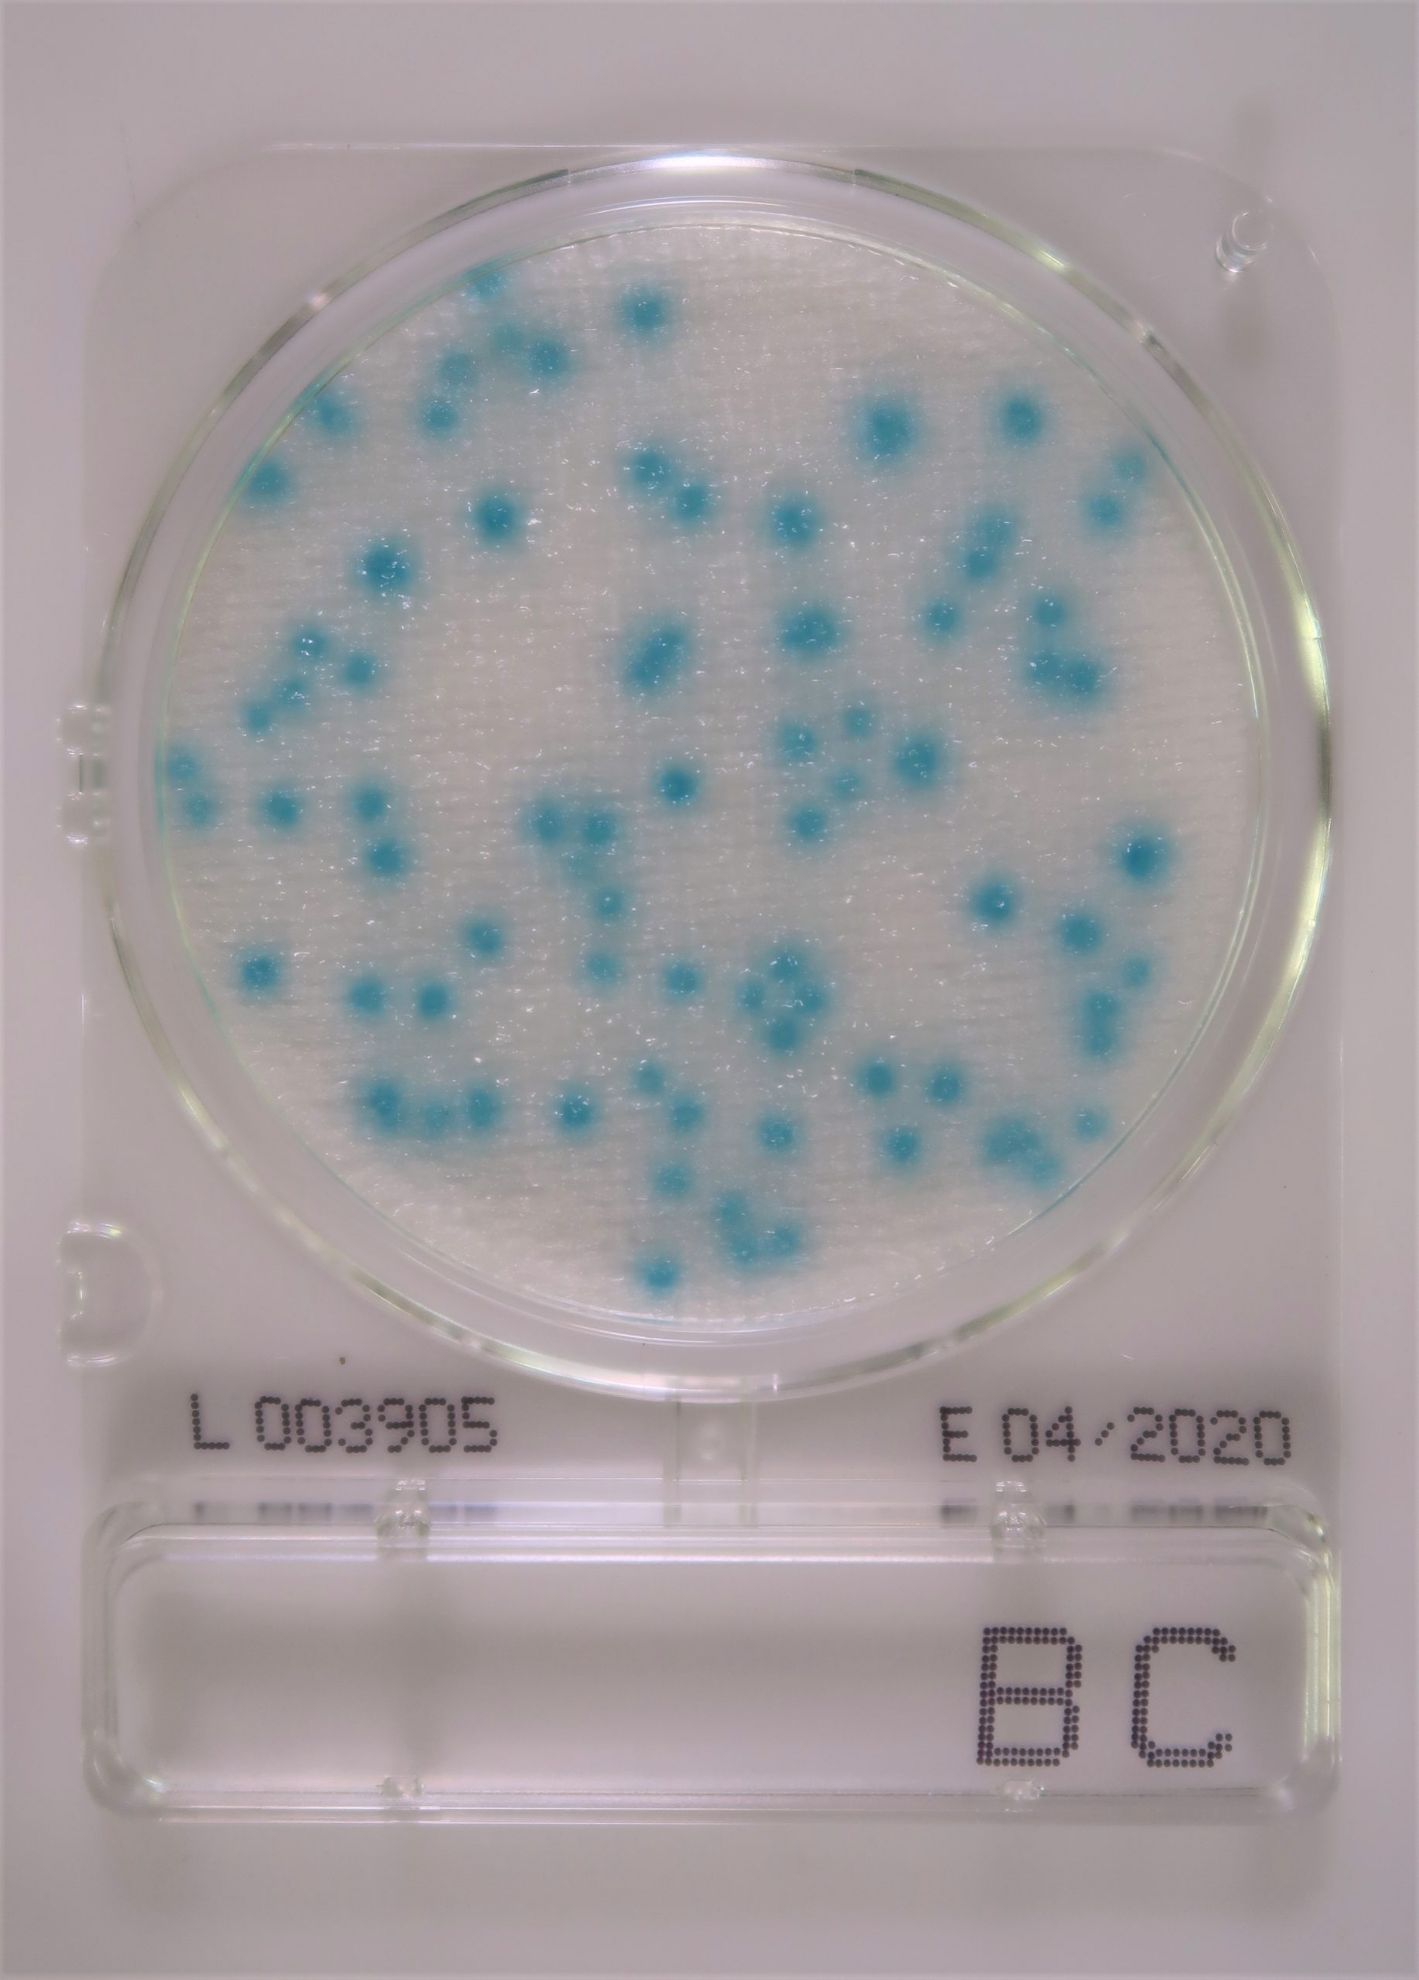

Compact Dry™ Prepared Media Plates - 54068-CS
Compact Dry™ is a simple and safe procedure to determine and quantify microorganisms in food and beverage, raw materials, cosmetics and pharmaceutical industries and internal environmental monitoring. The ready-to-use Compact Dry™ chromogenic plates are suitable for both in-process and final product controls.
- Ready-to-use
- Self-diffusing media - no need for a spreader
- Room temperature storage vs competitive products with storage at temperatures less than or equal to 8ºC
- Rigid transparent plates with removable lid - no leakage
- Innovative stacking design
- Easy to label
- Ability to subculture without damage to colonies
- Widest available parameters and broadest application
- Convenient, fast and accurate results
The Gram-positive bacterium Bacillus cereus is able to produce long lasting spores and is commonly found in soil and water. Therefore, it enters the food processing chain relatively easy. B. cereus can spoil foods; furthermore, its emetic and diarrheagenic enterotoxins cause vomiting and diarrhea after consumption. Routine testing procedures for B. cereus are thus recommended.
Compact Dry™ BC plates are incubated at 30 °C for 24 hours. Due to the chromogenic substances in the medium, B. cereus grows as green-blue colonies. If bacteria other than Bacillus cereus grow on the plate, they usually produce white colonies. The non-pathogenic organism Bacillus thuringiensis which is a close relative to B. cereus has the same biochemical properties. It can therefore also grow and produce green-blue colonies on Compact Dry™ BC.
You've got questions, we've got answers.
Reach out and let's see what we can do together.